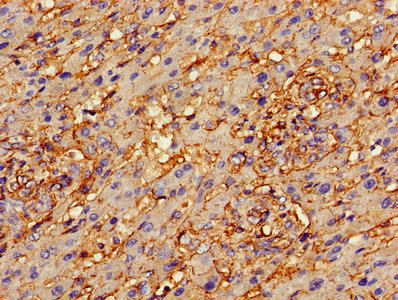

-
中文名稱:ANXA2兔多克隆抗體
-
貨號:CSB-PA001840HA01HU
-
規格:¥440
-
圖片:
-
Western Blot
Positive WB detected in: Hela whole cell lysate, K562 whole cell lysate, NIH/3T3 whole cell lysate, A549 whole cell lysate, PC-3 whole cell lysate, U251 whole cell lysate, Mouse lung tissue, Mouse liver tissue, Mouse kidney tissue
All lanes: ANXA2 antibody at 3µg/ml
Secondary
Goat polyclonal to rabbit IgG at 1/50000 dilution
Predicted band size: 39, 41 kDa
Observed band size: 39 kDa -
Immunohistochemistry of paraffin-embedded human liver cancer using CSB-PA001840HA01HU at dilution of 1:100
-
Immunofluorescent analysis of Hela cells using CSB-PA001840HA01HU at dilution of 1:100 and Alexa Fluor 488-congugated AffiniPure Goat Anti-Rabbit IgG(H+L)
-
Immunoprecipitating ANXA2 in Hela whole cell lysate
Lane 1: Rabbit control IgG instead of CSB-PA001840HA01HU in Hela whole cell lysate. For western blotting, a HRP-conjugated Protein G antibody was used as the secondary antibody (1/2000)
Lane 2: CSB-PA001840HA01HU (8µg) + Hela whole cell lysate (500µg)
Lane 3: Hela whole cell lysate (20µg) -
Immunohistochemistry of paraffin-embedded human lung tissue using CSB-PA001840HA01HU at dilution of 1:100
-
-
其他:
產品詳情
-
產品描述:
The product CSB-PA001840HA01HU is a polyclonal antibody produced in the rabbit immunized by a synthetic peptide of recombinant human Annexin A2 protein (ANXA2) (2-339AA). It is suitable for the detection of ANXA2 protein of human and mouse origin. The ANXA2 protein exerts diverse functions in multiple biological processes, such as endocytosis, exocytosis, membrane domain organization, actin remodeling, signal transduction, protein assembly, transcription and mRNA transport, as well as DNA replication and repair. This unconjugated ANXA2 antibody exists as an IgG isoform. Its purity is greater than 95% using protein G purification. It has been quality tested in four applications, including ELISA, WB, IHC, and IP.
-
產品名稱:Rabbit anti-Homo sapiens (Human) ANXA2 Polyclonal antibody
-
Uniprot No.:
-
基因名:
-
別名:Annexin A2 antibody; Annexin II antibody; Annexin II; heavy chain antibody; Annexin-2 antibody; ANX 2 antibody; ANX2 antibody; ANX2L4 antibody; ANXA2 antibody; ANXA2_HUMAN antibody; arylsulfatase B antibody; CAL1H antibody; Calpactin I heavy chain antibody; calpactin I heavy polypeptide (p36) antibody; Calpactin I heavy polypeptide antibody; Calpactin-1 heavy chain antibody; chromobindin 8 antibody; Chromobindin-8 antibody; Epididymis secretory protein Li 270 antibody; HEL S 270 antibody; LIP2 antibody; Lipocortin II antibody; LPC2 antibody; LPC2D antibody; p36 antibody; P36 protein antibody; PAP-IV antibody; Placental anticoagulant protein IV antibody; Protein I antibody
-
宿主:Rabbit
-
反應種屬:Human, Mouse
-
免疫原:Recombinant Human Annexin A2 protein (2-339AA)
-
免疫原種屬:Homo sapiens (Human)
-
標記方式:Non-conjugated
本頁面中的產品,ANXA2 Antibody (CSB-PA001840HA01HU),的標記方式是Non-conjugated。對于ANXA2 Antibody,我們還提供其他標記。見下表:
-
克隆類型:Polyclonal
-
抗體亞型:IgG
-
純化方式:>95%, Protein G purified
-
濃度:It differs from different batches. Please contact us to confirm it.
-
保存緩沖液:Preservative: 0.03% Proclin 300
Constituents: 50% Glycerol, 0.01M PBS, PH 7.4 -
產品提供形式:Liquid
-
應用范圍:ELISA, WB, IHC, IF, IP
-
推薦稀釋比:
Application Recommended Dilution WB 1:500-1:5000 IHC 1:20-1:200 IF 1:50-1:200 IP 1:200-1:2000 -
Protocols:
-
儲存條件:Upon receipt, store at -20°C or -80°C. Avoid repeated freeze.
-
貨期:Basically, we can dispatch the products out in 1-3 working days after receiving your orders. Delivery time maybe differs from different purchasing way or location, please kindly consult your local distributors for specific delivery time.
-
用途:For Research Use Only. Not for use in diagnostic or therapeutic procedures.
引用文獻
- Identification by proteomics of oviductal sperm-interacting proteins Julie Lamy.et al,journal of reproduction and fertility,2018
相關產品
靶點詳情
-
功能:Calcium-regulated membrane-binding protein whose affinity for calcium is greatly enhanced by anionic phospholipids. It binds two calcium ions with high affinity. May be involved in heat-stress response. Inhibits PCSK9-enhanced LDLR degradation, probably reduces PCSK9 protein levels via a translational mechanism but also competes with LDLR for binding with PCSK9.
-
基因功能參考文獻:
- Mechanistic studies revealed that FOXD2AS1 upregulated the expression of the miR206 target gene ANXA2 in hepatocellular carcinoma by acting as a miR206 sponge. PMID: 30272362
- study has localised AnxA2/S100A10 complexes to key anatomical locations in the placenta and suggests a role for this complex in amniotic epithelium, trophoblasts and syncytium, in addition to its well-known roles in endothelial cells PMID: 30143909
- Inhibition of ANXA2 will affect the expression of downstream targets and downstream signaling pathways, leading to the suppression of the malignant progression of tumors. PMID: 30355917
- our data suggest that overexpression of peroxiredoxin-2, annexin A2, and heat shock protein beta-1 was correlated with tumor invasion, metastasis, and poor prognosis, and therefore, these proteins may serve as potential diagnostic and therapeutic biomarkers. PMID: 29332450
- aptamer wh6 can block MM cell adhesion to ANXA2 and block the proliferation of MM cells induced by ANXA2 PMID: 29906496
- The results demonstrated that ANX2 and stromal tenascin C regulated invasion in addition to stemness and anoikis resistance, which are crucial for metastasis in the progression of pancreatic ductal adenocarcinoma. PMID: 29749431
- highly expressed in gastric cancer, related to tumor size, histological differentiation, lymph node metastasis PMID: 29097873
- models for annexin A2-mediated vesicle aggregation mechanisms. PMID: 29567212
- Our profiling data provided a rich source for further study of the molecular mechanisms of acquired drug resistance inneuroblastoma ( NB). Further study may determine the role of ANXA2 as a prognostic biomarker and a potential therapeutic target for patients with multidrug-resistant NB. PMID: 28814318
- These results suggested that increased ANXA2 and less expressed beta-catenin were correlated to adenomyosis-associated dysmenorrhea PMID: 28547742
- These data suggested that Annexin A2 induces cisplatin resistance of non-small cell lung cancer (NSCLC)via regulation of JNK/c-Jun/p53 signaling, and provided an evidence that blockade of Annexin A2 could serve as a novel therapeutic approach for overcoming drug resistance in NSCLCs PMID: 28886730
- Results show that Anxa2-Tyr23 phosphorylation is necessary for proliferation, invasion, and metastasis of breast cancer cells in vitro and in vivo. Tyr23-phosphorylated Anxa2 binds to STAT3 and serves as a key regulator of STAT3 signaling. PMID: 28470457
- annexin A2 can potentially predict the development of pre-eclampsia. The low annexin A2 levels (<0.89 ng/ml) together with higher blood pressure and proteinuria constitute a higher risk to develop preeclampsia. PMID: 28501283
- Variants in the Annexin A2 (ANXA2) gene directly influence plasma LDL-C levels. PMID: 28456096
- this study showed that Annexin A2 inhibition suppresses proliferation and invasion in ovarian cancer via beta-catenin/EMT, proposing the potential role of Annexin A2 in the prevention and treatment of ovarian cancer PMID: 28440436
- FNDC3B and ANXA2 expression correlate negatively with patient survival in hepatocellular carcinoma PMID: 27385217
- UBAP2 formed a complex with Annexin A2 and promoted the degradation of Annexin A2 protein by ubiquitination, and then inhibited HCC progression. PMID: 27121050
- results indicate that ANXA2 plays an important role to enhance the malignant behaviors of Hepatocellular carcinoma cells, and the enhancement is closely based on its remodeling to cell structures PMID: 27060670
- Thus, tight regulation of AnxA2 function is an integral aspect of cellular homeostasis. The presence of AnxA2 in cancer cell-derived exosomes, as well as the potential regulation of exosomal AnxA2 by phosphorylation or other PTMs, are topics of great interes PMID: 28867585
- Restoration of miR-101 expression reversed chemoresistance of drug-resistant gastric cancer cells by inhibiting viability and enhancing apoptosis via targeting ANXA2. PMID: 28609840
- Annexin 2A (ANXA2) is over-expressed in Glioblastoma (GBM) and positively correlates with patient outcome. PMID: 27429043
- Results confirm that both circRNA expression and even ANXA2 expression could be used as biomarkers of RR-MS with good values of specificity and sensitivity. PMID: 28651352
- This study demonstrated that the expression level of AnxA2 was significantly higher in recurrent adamantinomatous craniopharyngioma compared with primary ones. AND AnxA2(+) adamantinomatous craniopharyngioma cells exhibited enhanced proliferation and migration ability compared with AnxA2(-) adamantinomatous craniopharyngioma cells. PMID: 27640198
- Cercvical cancer stem cells express annexin II, an HPV co-receptor. PMID: 27008711
- Annexin A2 (ANXA2) and prostate-specific antigen (PSA) proteins measured from biopsy tumour regions are unlikely to be good biomarkers for prediction of the clinical outcome of prostate cancer presenting with apparently localized disease. PMID: 29187477
- anti-ANXA2 antibodies play a role in thrombotic mechanisms leading to recurrent pregnancy loss and placental vascular disease PMID: 27631133
- results suggest that mycoplasma induces a resistance to multiple drugs in hepatocarcinoma cells which required the interaction of P37 and Annexin A2. The pathway downstream this interaction needs to be explored PMID: 28976984
- Findings indicate that Munc13-4 supports acute WPB exocytosis by tethering WPBs to the plasma membrane via AnxA2-S100A10. PMID: 28450451
- Detecting ANXA2 and ANXA4 expression may aid the evaluation of cervical carcinoma prognosis. PMID: 27402115
- our studies show that this G-motif represents a novel and essential determinant for axonal localization of the Anxa2 mRNA mediated by the SMN complex. PMID: 28258160
- The data data suggest that interactions between HIV-1 gp120 and A2 exist, though this interaction may be indirect. PMID: 27863502
- Exosome-associated Annexin II plays an important role in angiogenesis and breast cancer metastasis. PMID: 27760843
- ANXA2 stromal expression might play a key role in aggressive tumor phenotype associated with increased EMT CTCs release, however, other factors beyond ANXA2 are responsible for coagulation activation mediated by CTCs in breast cancer patients. PMID: 28476852
- annexin A2 contributes to lung injury and fibrotic disease by mediating the fibrogenic actions of FXa. PMID: 28283478
- Annexin A2 and HB-EGF are overexpressed and are being secreted into serum in Her-2 negative breast cancer patients. PMID: 27496793
- results indicate that ANXA2 facilitates PS-ASO trafficking from early to late endosomes where it may also contribute to PS-ASO release PMID: 27378781
- Annexins A2 and A8 in endothelial cell exocytosis and the control of vascular homeostasis PMID: 27451994
- Rack1 regulated P-Glycoprotein activity, which was necessary for adriamycin-induced P-Glycoprotein - mediated phosphorylation of Anxa2 and Erk1/2. PMID: 27754360
- The presence of vascular lesions in lupus nephritis (LN) appears to be associated with significant differences in the vascular expression of ANXA2. PMID: 26511441
- expression elevated in lung squamous cell carcinoma tissue PMID: 28178129
- annexin A2 but not follistatin is expressed in hepatocellular carcinoma PMID: 26189841
- Our results place ANXA2 at the apex of a regulatory cascade that determines glioblastoma mesenchymal transformation and validate aSICS as a general methodology to uncover regulators of cancer subtypes. PMID: 27667176
- Overexpression of ANXA2 is associated with colorectal cancer. PMID: 27468721
- Annexin A2, up-regulated by IL-6, promotes ligament ossification in ankylosing spondylitis patients. PMID: 27697640
- highly specific 30 kDa plant lectin could dissociate AnxA2 from endogenous lectin galectin-3 interaction at the cell surface. This dissociation could down-regulate Bcl-2 family proteins, cell proliferation, and migration simultaneously triggering cell apoptosis PMID: 26438086
- Data show that ONECUT2, IGF2BP1, and ANXA2 proteins were confirmed to be microRNA-9 (miR-9) targets and aberrantly upregulated in hepatocellular carcinoma (HCC). PMID: 26547929
- annexin A2 and S100A10 expressions are powerful predictors of serous ovarian cancer outcome. PMID: 26925708
- expression of ANXA2 is associated with tumorigenesis and therapeutic resistance of nasopharyngeal carcinoma PMID: 26196246
- Anxa2 binds to STAT3 and promotes epithelial to mesenchymal transition in breast cancer. PMID: 26307676
- the role of Axna2 is instructive for understanding the development of RA, suppress the effect of Axna2 might provide a new potential measure for treatment of RA. PMID: 26963384
顯示更多
收起更多
-
亞細胞定位:Secreted, extracellular space, extracellular matrix, basement membrane. Melanosome. Note=In the lamina beneath the plasma membrane. Identified by mass spectrometry in melanosome fractions from stage I to stage IV. Translocated from the cytoplasm to the cell surface through a Golgi-independent mechanism.
-
蛋白家族:Annexin family
-
數據庫鏈接:
Most popular with customers
-
-
YWHAB Recombinant Monoclonal Antibody
Applications: ELISA, WB, IHC, IF, FC
Species Reactivity: Human, Mouse, Rat
-
Phospho-YAP1 (S127) Recombinant Monoclonal Antibody
Applications: ELISA, WB, IHC
Species Reactivity: Human
-
-
-
-
-